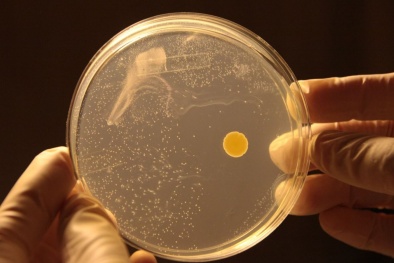
Sản xuất điện từ không khí loãng

Thương hiệu Hội nhập
Công nghệ

Đổi mới sáng tạo – động lực từ toàn dân đến quốc gia
(VietQ.vn) - Đổi mới sáng tạo ở Việt Nam không chỉ là nhiệm vụ của doanh nghiệp hay các nhà khoa học, mà đã trở thành phong trào toàn dân. Khi cả cộng đồng cùng chung tay, đổi mới sáng tạo được lan tỏa thành lối sống, mở ra động lực để đất nước bứt phá.
-

BMW iFace - công nghệ nhận diện khuôn mặt và mắt đầu tiên trên môtô
Những công nghệ khiến đường sá trở nên thông minh hơn
Báo chí đóng vai trò quan trọng trong thúc đẩy chuyển đổi xanh, tăng trưởng xanh
Chính thức khóa 1 chiều sim điện thoại chưa chuẩn hóa thông tin thuê bao
Doanh nghiệp cần địa phương hóa giải pháp đổi mới sáng tạo
Hợp chất triển vọng trong điều trị bệnh mù bẩm sinh
Trí tuệ nhân tạo có thể làm 'xáo trộn' cuộc sống của con người?
-

Đổi mới sáng tạo: Từ 'bài toán khó' của đất nước thành 'cơ hội mới' cho tương lai
-

Nhiều bệnh viện lớn bị tấn công mạng, dữ liệu bệnh nhân bị rao bán trên diễn đàn hacker
Tin mới Công nghệ 24h

Thử nghiệm lốp xe không cần bơm hơi
(VietQ.vn) - Nhà sản xuất lốp xe hàng đầu Nhật Bản Bridgestone đang tiến hành thử nghiệm loại lốp không cần bơm hơi.

Chế tạo thành công máy in 3D từ nhựa tái chế
(VietQ.vn) - PGS. Nguyễn Huy Tùng, Trung tâm Nghiên cứu vật liệu polymer, Đại học Bách khoa Hà Nội và cộng sự vừa nghiên cứu thành công máy in 3D từ nhựa tái chế mở ra nhiều tiềm năng ứng dụng trong lĩnh vực còn mới này.

Rong biển cảm biến có khả năng theo dõi sức khỏe và thể chất
(VietQ.vn) - Một nhóm nhà khoa học tại Đại học Tổng hợp Sussex (Anh) đã thử nghiệm thành công một loại cảm biến sức khỏe giúp ích cho việc theo dõi và chăm sóc sức khỏe cá nhân.

Viettel thực hiện thành công chiến lược Việt Nam hóa mạng lưới viễn thông
(VietQ.vn) - Ngày 24/03/2023, Tổng Công ty Công nghiệp công nghệ cao Viettel (Viettel High Tech) và Tổng Công ty mạng lưới Viettel (Viettel Network) đã chính thức triển khai thành công hệ thống tổng đài thoại cho mạng 4G/5G (hệ thống IMS) do VHT nghiên cứu, sản xuất. Sự kiện này đánh dấu việc Viettel đã hoàn thành chiến lược Việt Nam hóa mạng lưới viễn thông.

Đổi mới sáng tạo - động lực cốt lõi mang lại sự phát triển kinh tế và nâng cao mức sống
(VietQ.vn) - Theo chuyên gia, đổi mới sáng tạo luôn được xem là động lực cốt lõi mang lại sự phát triển kinh tế và nâng cao mức sống.

Ứng dụng trí tuệ nhân tạo tăng năng suất ngành nông nghiệp
(VietQ.vn) - Tại Việt Nam, ứng dụng trí tuệ nhân tạo AI vào nông nghiệp vẫn còn khá mới mẻ nhưng đang thu hút sự quan tâm của Chính phủ cũng như các doanh nghiệp sản xuất vì những ưu thế mà nó mang lại so với nông nghiệp truyền thống.

Chuyển đổi số: Xu hướng chuyển đổi kép 'số và xanh'
(VietQ.vn) - Diễn đàn “Chuyển đổi số: Nhanh hơn, Thông minh hơn, Xanh hơn” vừa diễn ra sáng nay (21/3) do Báo Đầu tư tổ chức mở ra luồng thông tin mới, thiết thực về những xu hướng chuyển đổi kép “số và xanh” trong các lĩnh vực sản xuất, tài chính-ngân hàng, e-commerce/logistics, những chính sách khuyến khích của chính phủ, cùng những đòn bẩy tăng trưởng thông minh hơn và xanh hơn.

Sở hữu trí tuệ là công cụ thúc đẩy hoạt động đổi mới sáng tạo
(VietQ.vn) - Sở hữu trí tuệ là công cụ thúc đẩy hoạt động đổi mới sáng tạo, là một trong các trụ cột quan trọng để mỗi quốc gia phát triển bền vững trong xu thế hội nhập quốc tế và cũng là cơ hội để đón nhận các thành quả của CMCN 4.0.

Sản xuất nhựa sinh học từ gạo
(VietQ.vn) - Một hãng công nghệ ở Fukushima đã khởi động dự án sản xuất nhựa sinh học từ gạo. Đây là một trong những giải pháp nhằm tìm đầu ra cho gạo của địa phương.

Còn nhiều rào cản thách thức trong sử dụng phương tiện giao thông điện
(VietQ.vn) - Những hạn chế, rào cản và thách thức chính cản trở việc sử dụng xe điện bao gồm tuổi thọ pin kém, thời gian sạc pin lâu, khó mua linh kiện thay thế. Dịch vụ cung ứng và hạ tầng kỹ thuật hỗ trợ tiếp cận phương tiện giao thông điện chưa đáp ứng tốt kỳ vọng của người tiêu dùng.

Hoàn thiện chính sách về khoa học, công nghệ và đổi mới sáng tạo
(VietQ.vn) - Thời gian qua, Bộ KH&CN đã có nhiều nỗ lực trong công tác xây dựng, hoàn thiện chính sách, pháp luật và triển khai các nhiệm vụ trọng tâm trong lĩnh vực khoa học, công nghệ và đổi mới sáng tạo.

Ngày Sở hữu trí tuệ thế giới 2023: Phụ nữ với Sở hữu trí tuệ - Thúc đẩy đổi mới sáng tạo
(VietQ.vn) - Tổ chức Sở hữu Trí tuệ Thế giới (WIPO) đã chính thức công bố chủ đề của Ngày Sở hữu trí tuệ thế giới 2023 là: Phụ nữ với Sở hữu trí tuệ - Thúc đấy đổi mới sáng tạo. Nhằm đề cao sức sáng tạo và khuyến khích phụ nữ tìm hiểu, sử dụng hiệu quả công cụ sở hữu trí tuệ.

Hệ thống cửa sổ lỏng giúp tiết giảm chi phí năng lượng
(VietQ.vn) - Các nhà nghiên cứu của Đại học Kỹ thuật Toronto ở Canada đã phát triển một hệ thống chất lỏng nhiều lớp (cửa sổ lỏng) có thể giảm chi phí năng lượng để sưởi ấm, làm mát và chiếu sáng các tòa nhà.
Sản xuất điện từ không khí loãng
(VietQ.vn) - Các nhà khoa học Australia đã phân lập thành công một loại enzyme từ vi khuẩn phổ biến trong đất, có thể chuyển đổi một lượng nhỏ hydro từ không khí thành điện năng.

Israel phát triển robot y tế phẫu thuật não nhỏ như cây bút
(VietQ.vn) - Một công ty công nghệ Israel phát triển một robot có kích thước nhỏ hơn cây bút viết nhưng có khả năng hỗ trợ tốt quá trình phẫu thuật cho bệnh nhân u não.

Đồng hành, hỗ trợ phái đẹp trên hành trình theo đuổi ngành công nghệ
(VietQ.vn) - Hội thảo Women in data science 2023 (WiDS) với chủ đề “Make a difference!” giới thiệu, đào tạo những kỹ năng trong ngành khoa học dữ liệu. Trong tháng Ba- tháng tôn vinh nữ giới, WiDS hướng đến đồng hành, hỗ trợ và trao quyền nhiều hơn cho phái đẹp trên hành trình theo đuổi ngành công nghệ.

Việt Nam có 13 nhà khoa học lọt vào bảng xếp hạng thế giới
(VietQ.vn) - 13 nhà khoa học Việt Nam đang làm việc trong nước được xếp hạng ở 7 lĩnh vực: Khoa học máy tính, Kỹ thuật và Công nghệ, Khoa học Môi trường, Khoa học Vật liệu, Kỹ thuật cơ khí và Hàng không vũ trụ, Y học cộng đồng và Khoa học xã hội và nhân văn.

Tương lai năm 2023: Robot sẽ xử lý 40% công việc nhà
(VietQ.vn) - Chuyên gia dự đoán khi cuộc cách mạng trí tuệ nhân tạo nổ ra, 40% công việc liên quan đến nội trợ sẽ bị robot thay thế trong vòng 10 năm tới.

Biến tri thức thành của cải vật chất để phát triển xã hội
(VietQ.vn) - Cần có biện pháp để khai thác các chính sách phát triển tài sản trí tuệ, biến tri thức thành của cải vật chất để phát triển xã hội; tăng cường đẩy mạnh hợp tác quốc tế trong các hoạt động sở hữu trí tuệ.

PV GAS và BSR chia sẻ kinh nghiệm về chuyển đổi số
(VietQ.vn) - Nhằm tăng cường các hoạt động trao đổi, chia sẻ, học hỏi giữa các đơn vị trong ngành dầu khí, Tổng công ty Khí Việt Nam (PV GAS) và Công ty Cổ phần Lọc hóa dầu Bình Sơn (BSR) đã tổ chức Hội thảo “Chia sẻ kinh nghiệm về chuyển đổi số - ERP, đào tạo phát triển nhân lực và Vận hành, bảo dưỡng, sửa chữa công trình dầu khí”.





